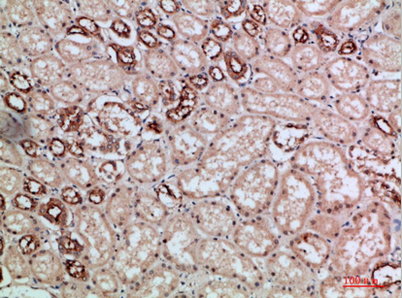

$148.00/50µL $248.00/100µL
| 50 µL | $148.00 |
| 100 µL | $248.00 |
| Product name: | Villin rabbit pAb |
| Reactivity: | Human;Mouse;Rat |
| Alternative Names: | villin 1 |
| Source: | Rabbit |
| Dilutions: | WB 1:500-2000, ELISA 1:10000-20000 |
| Immunogen: | Synthesized peptide derived from Villin at AA range: 601-650 |
| Storage: | -20°C/1 year |
| Clonality: | Polyclonal |
| Isotype: | IgG |
| Concentration: | 1 mg/ml |
| Observed Band: | 90kD |
| GeneID: | 7429 |
| Human Swiss-Prot No: | P09327 |
| Cellular localization: | Cytoplasm, cytoskeleton. Cell projection, lamellipodium. Cell projection, ruffle. Cell projection, microvillus. Cell projection, filopodium tip . Cell projection, filopodium . Relocalized in the tip of cellular protrusions and filipodial extensions upon infection with S.flexneri in primary intestinal epithelial cells (IEC) and in the tail-like structures forming the actin comets of S.flexneri. Redistributed to the leading edge of hepatocyte growth factor (HGF)-induced lamellipodia (By similarity). Rapidly redistributed to ruffles and lamellipodia structures in response to autotaxin, lysophosphatidic acid (LPA) and epidermal growth factor (EGF) treatment. . |
| Background: | This gene encodes a member of a family of calcium-regulated actin-binding proteins. This protein represents a dominant part of the brush border cytoskeleton which functions in the capping, severing, and bundling of actin filaments. Two mRNAs of 2.7 kb and 3.5 kb have been observed; they result from utilization of alternate poly-adenylation signals present in the terminal exon. [provided by RefSeq, Jul 2008], |